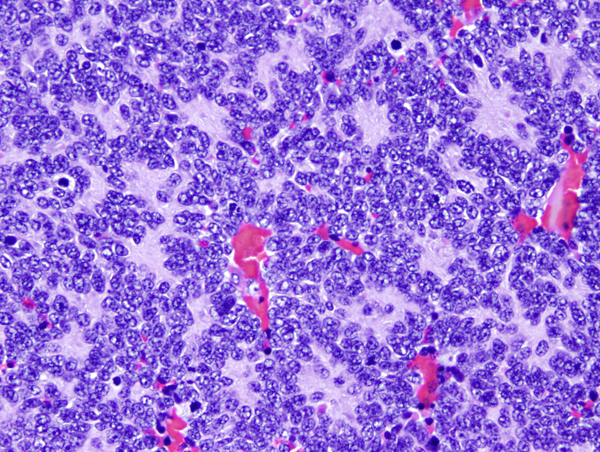

What syndromes are associated with
Pilocytic Astrocytomas
NF-1
Possibly Li-Fraumeni, Noonan & TS?
What syndromes are associated with choroid papillomas?
Aicardi
Li-Fraumeni
&
Hypomelanosis of Ito
(tX;17(q12;p13))
What syndromes are associated with ependymomas?
NF2
What syndromes are associated with Medulloblastoma?
Gorlin
Turcot Type 2
&
Li-Fraumeni
What tumor belongs to this pathway?

Pilocytic astrocytoma
A duplication of results in KIAA1549-BRAF fusion protein with KIAA1549 replacing the BRAF N-terminal regulatory domain is associated with what tumor and how often?
Pilocytic astrocytoma:
70%
What is unique about pilocytic astrocytoma with loss of wild type NF1?
Grow in association with optic nerve
BRAF V600E mutation is associated with what CNS tumors?
Supratentorial pilocytic astrocytomas, gangliogliomas, PXA & DNET
What are the WHO grades for ganglioglioma and anaplastic ganglioglioma
WHO I
&
WHO III
(There is no WHO II)
What syndrome is associated with cerebellar ganglioglioma?
Cowden syndrome.
Bonus: gangliogloma in this location warrants genetic testing for Cowden syndrome.
What is the most common pediatric CNS malignancy?
2nd most common?
Assuming appropriate histology and stains, what required feature is necessary to make a diagnosis of medulloblastoma?
Primary tumor present in the cerebellum.
What is the immunoprofile of medulloblastoma?
What is in the differential?
Synaptophysin, GFAP, INI-1 retained.
Other embryonal tumors (medulloepithelioma, pineoblastoma, CNS neuroblastoma, embryonal mutated or NOS) and high grade gliomas.
What are the 4 (or 5) different diagnostic categories of medulloblastoma?
Other molecular associations, syndrome, histologic type and risk?
What is the most common subtype of medulloblastoma?
2nd, 3rd, 4th?
What ages do the various medulloblastoma subtypes present?
Large cerebellar mass in a 5 yo female.
Medulloblastoma, classic histology
(Probably WNT activated or Group 4)
Large cerebellar mass in a 2 year old male.
What is it? What is likely mutation? What syndrome to screen for? What is Px?

Medulloblastoma
SHH p53WT (PTCH1, SUFU)
Gorlin syndrome
Excellent px/low risk
What is the definitive treatment for medulloblastoma?
Complete surgical resection.
What is the ddx for medulloblastoma based on location?
Based on histology?
Location: Cerebellar astrocytoma, ependymom, hemangioblastoma, CNS Embryonal tumors
Histology: CNS Embryonal tumors, ATRT
C5-C6 nerve root damage
Erb palsy
Klumpke paralysis
Paralysis of wrists and digits due to trauma a C9-T1 nerve roots
What is this?

Area cerebrovasculosa: histologic appearance of anencephalic brain w/primitive superficial neural layer and subadjacent vascular layer.
Describe the types of Chiari malformations
Type 0: syringohydrocele without herniation
Type I: >5mm tonsilar herniation +/-syringocele; syndromic ass’n - Marfan, EDS
Type 1.5: >5mm herniation w/persistent syringomyelia
Type II: Arnold Chiari - <5mm tonsilar herniation w/low lying torcular herophili, tectal beaking, hydrocephalus w/clival hypoplasia & lumbosarcal meningomyelocele.
Type III: variable herniated elements w/occipital encephalocele
Type IV: ~cerebellar agenesis/hypoplasia